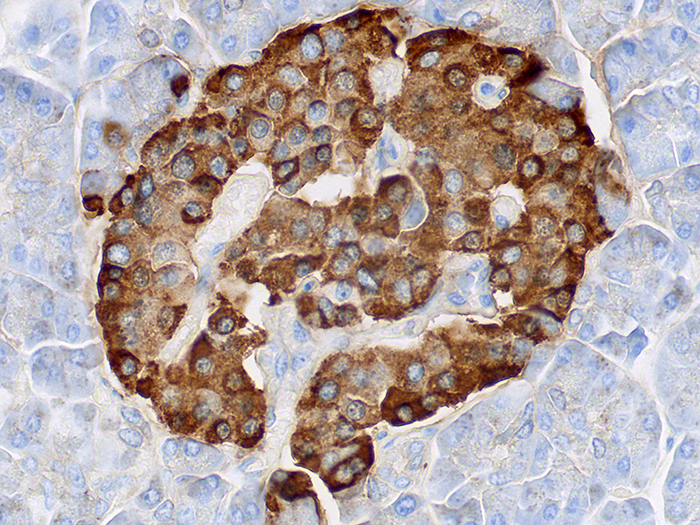
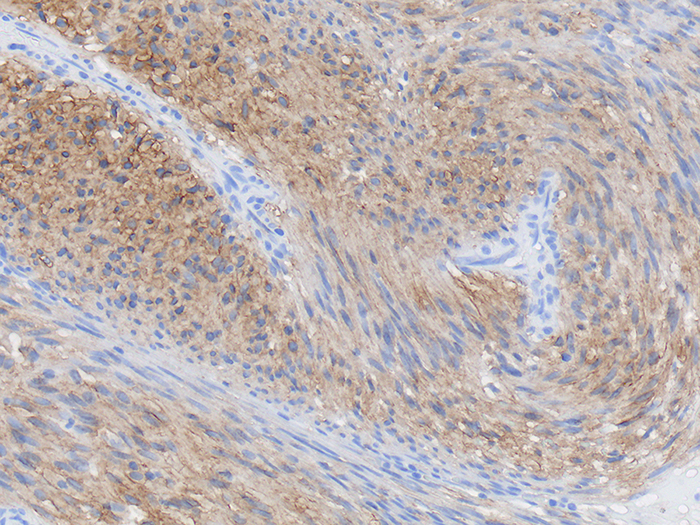
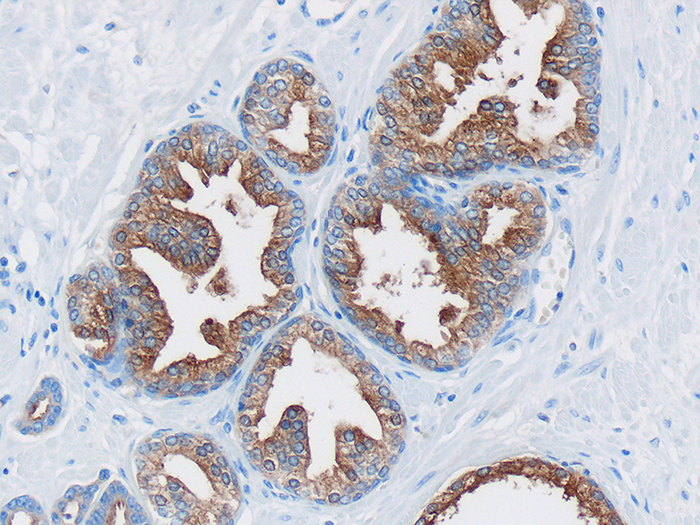
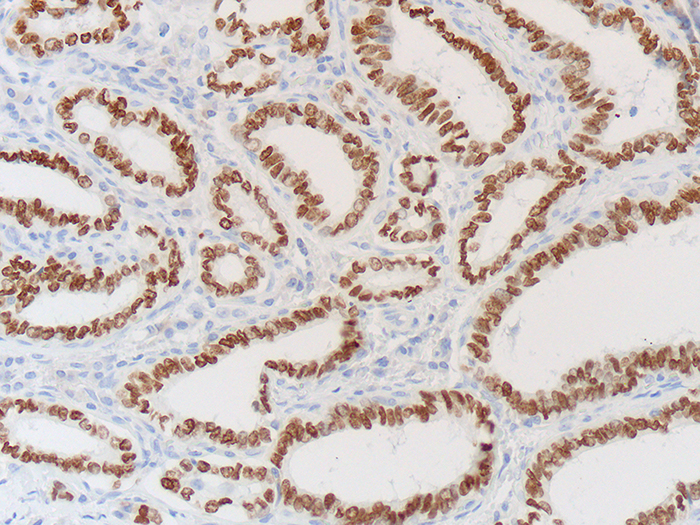

Positive Control Slides
Newcomer Supply has extensive selections of both histopathology and immunopathology control slides. We also have a custom tissue product line ideal for your specific needs. Additionally, you can request modifications to your controls through our special request program.
PRODUCT INFORMATION:
All controls are cut in serial sections.
10/set = 10 unstained slides and 1 stained slide
98/set = 98 unstained slides and 2 stained slides
| Tissue: | Positive staining tissue |
| Fixation: | Formalin 10% Phosphate Buffered |
| Section: | 4 microns |
| Placement: | Mid-high |
| Glass: | Superfrost™ Plus |
| Dried: | Air Dried |
| Orientation: | Horizontal |
| Reactivity: | Guaranteed product specific reactivity for one year from date of receipt. Revalidate after one year to verify continued reactivity |
| Storage: | 15-30°C in a light deprived and humidity-controlled environment |
| Intended Use: | To verify histological techniques and reagent reactivity |
Please note all controls are in human tissue unless otherwise indicated. Histopathology control slides are not quality controlled for IHC methods, as such, we cannot certify antigenicity. Our control slides are intended to verify histological techniques and reagent reactivity. Review the supplied stained slide with your pathologist prior to using unstained slides to ensure the intended analyte of interest is acceptable.
Histopathology
Amyloid
Due to the nature of the tissue the standard drying method for Amyloid Control Slides are oven dried
Amyloid, Animal
Due to the nature of the tissue the standard drying method for Amyloid Control Slides are oven dried
Gram, Multi-Tissue, Artificial
Control Slides are for the positive histochemical staining of gram positive and gram negative bacteria in separate tissue sections.


Tissue Microarray Construction Instruments
(See Tissue Microarray Instruments in our Grossing & Embedding Section)
Click Here for information, part numbers and pricing.
Immunopathology
CD30
Due to the nature of the tissue the standard drying method for CD30 Control Slides are oven dried
Hepatitis B Surface Antigen (HBsAG)
Due to the nature of the tissue the standard drying method for Hepatitis B Surface Antigen Control Slides are oven dried


Leucocyte Common Antigen (LCA), CD45
(See CD45, Leucocyte Common Antigen (LCA))
Click Here for information, part number and pricing.


PIN-4 Cocktail Multi-Tissue
(See CK5/14 + p63+ p504S Multi-Tissue)
Click Here for information, part number and pricing.


Tissue Microarray Construction Instruments
(See Tissue Microarray Instruments in our Grossing & Embedding Section)
Click Here for information, part numbers and pricing.
HistoCyte
Human
Human Abnormal
Breast
Pathological conditions:
-
-
- Carcinoma
- Ductal carcinoma in situ (DCIS)
- Fibrosis
- Infiltrating ductal carcinoma (IDC)
- Phyllodes
-
Cervix
Pathological conditions:
-
-
- Adenocarcinoma
- Carcinoma in situ (CIN)
- Clear cell carcinoma
- Squamous cell carcinoma
-
Lung (AFB) - Limited Availability
Slide set will not contain a complimentary H&E. For this tissue, a digital image will be available.
Lung (Alk 1) - Limited Availability
Slide set will not contain a complimentary H&E. For this tissue, a digital image will be available.
Animal
Animal Abnormal
Red Control Box
Special Request Control Slides on Red Control Box Slides
How to order Positive Control Slides on Red Control Box Slides
- Order the histopathology or immunopathology control slide of interest with the standard part number for either a 10/set or 98/set. Add a “SR” to the part # to signify the modification.
-
Order the Custom Glass for Red Control Box Slide for the size set (10/set or 98/set) that was ordered for control slides. This is done in a 1:1 ratio. (If you order 5 – 10/sets of control slides, you will need to order 5 – 10/sets of CCS-REDBOXA)
- Include Red Control Box Slide Details:
- Charged or non-charged
- Red Box on front or back of slide
- Painted end either ¾” or 1″



.jpg)